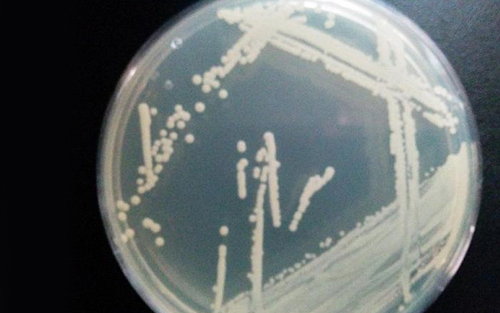

这是英国考文垂市索威河下游污水处理厂发现的超抗药性菌株
据国外媒体报道,目前,科学家警告称,英国考文垂市索威河下游污水处理厂发现高抗药性菌株,或将引发潜在超级细菌的威胁性。据悉,高抗药性细菌是英国沃里克大学专家在污水处理厂采集样本时探测到的,它们是人类粪尿中的大肠杆菌株,它可以产生超广谱β-内酰胺酶(ESBLs),这种酶可以破坏青霉素在内的许多抗生素。
超广谱β-内酰胺酶感染危害性较强,因为治疗方法十分有限,在严重情况下需要注射药物。沃里克大学环境微生物学讲师伊丽莎白-惠灵顿(Elizabeth Wellington)教授和研究同事采集分析了索威河上流和下流的沉积样本。
他们发现抗药性细菌对用于治疗疾病的抗生素十分重要,这些疾病包括:脑膜炎、败血症、医源性感染等。同时,他们发现英国污水处理厂上游抗药性大肠杆菌是下游的7倍以上。
这项研究表明抗药性细菌正在逐渐扩散,因为这种blaCTX-M-15基因型细菌能够适应生存环境。研究人员指出,当前需要严格水质控制和高水平污水治理,这将中止环境中抗药性细菌滋生的危险性,有效地抑制“超级细菌”的出现。
惠灵顿教授说:“如果你搅动抗药细菌滋生水中的沉积物,之后食用5毫升水,那么你将面临着患肠胃炎的危险,这将使你严重生病。如果抗药性细菌种群寄居在你消化系统中,之后泌尿系统感染,再通过排泄离开人体,这将扩大传播范围。”这项最新研究发表在近期出版的《抗菌化学疗法》杂志上。







